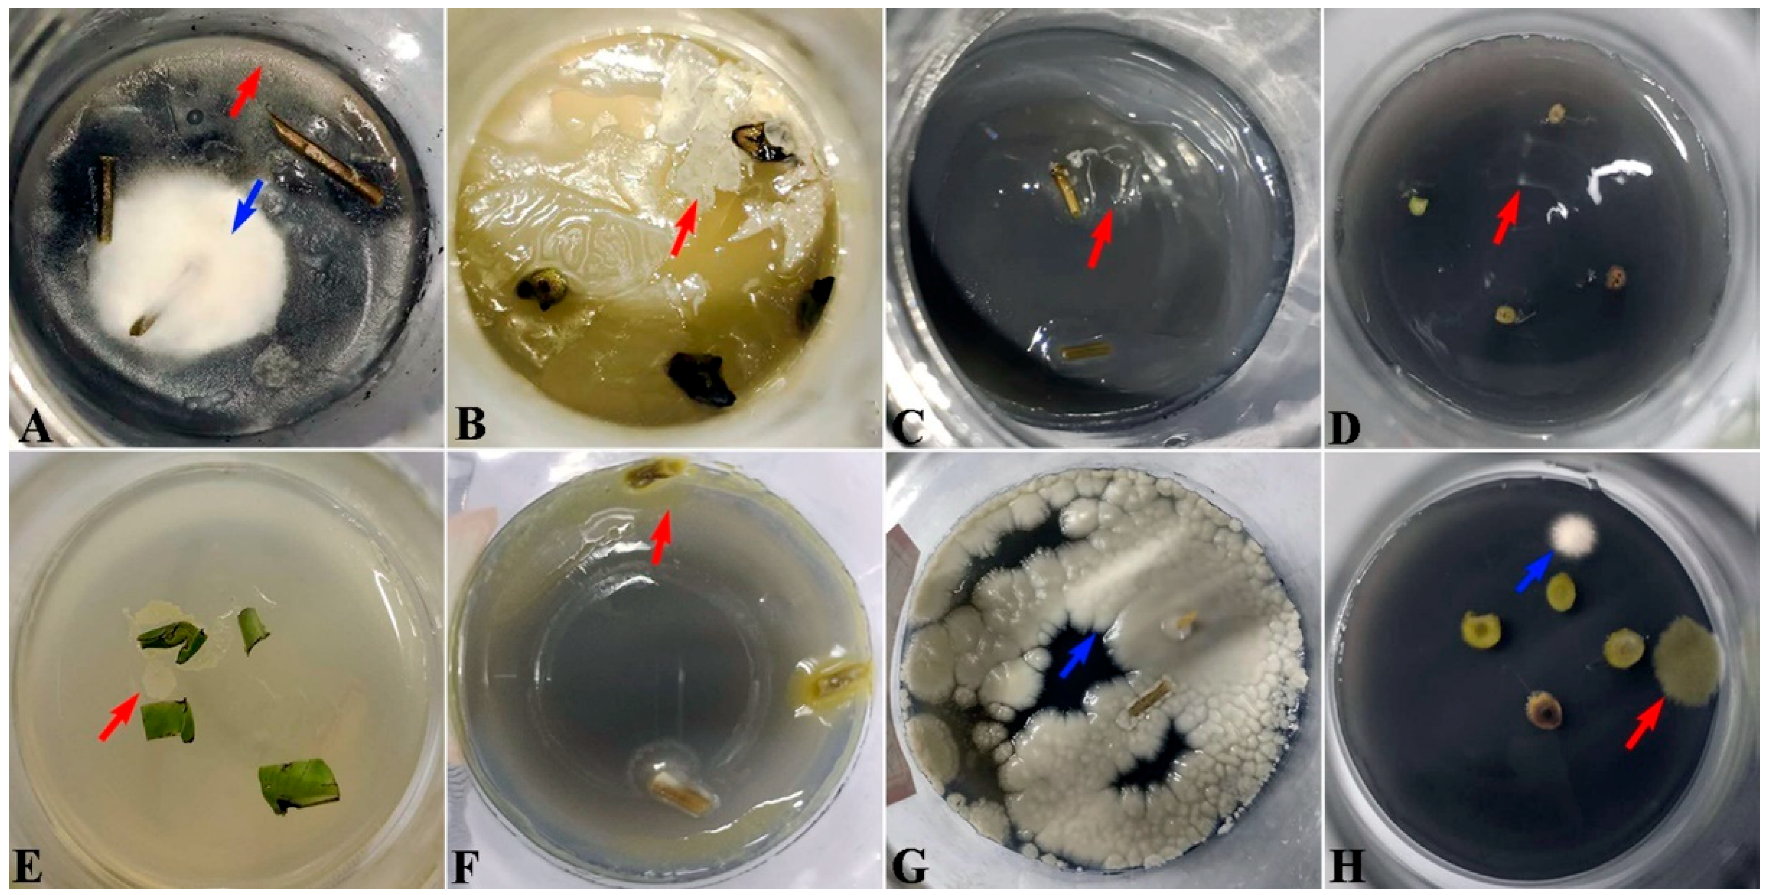
Microorganisms 10 02476 g001 Microorganisms 10 02476 g001
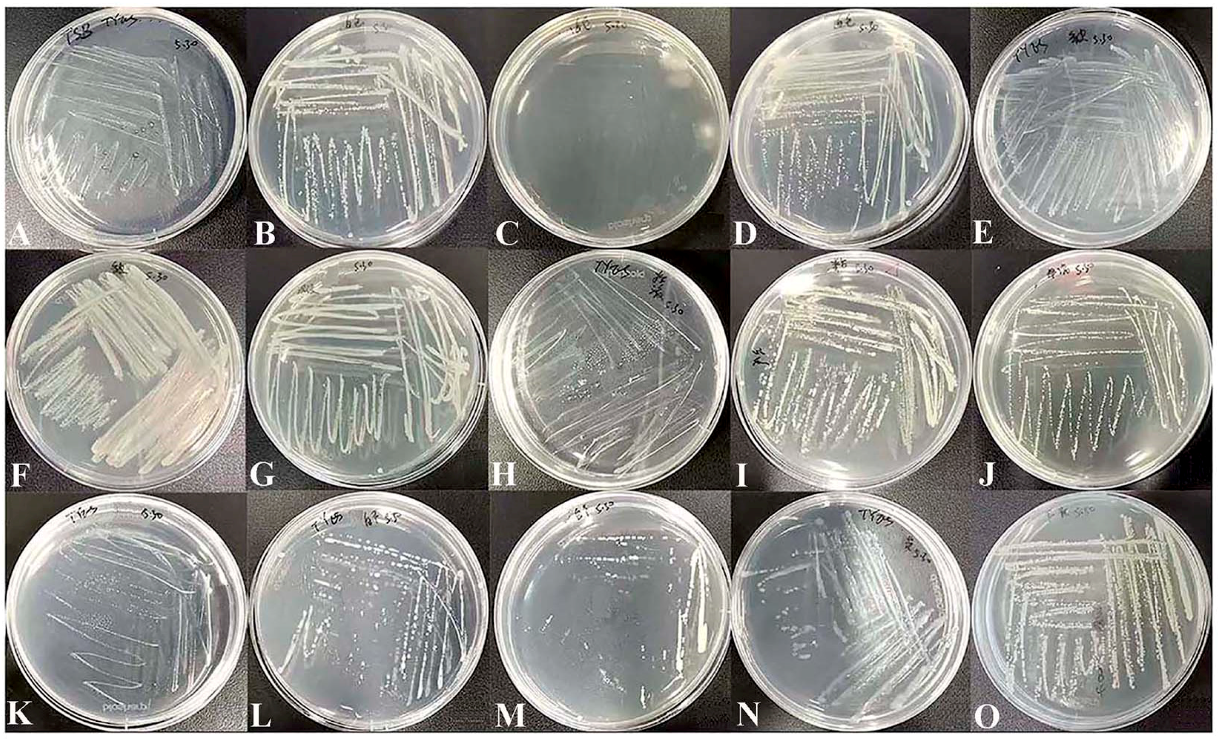
Microorganisms 10 02476 g002 Microorganisms 10 02476 g002
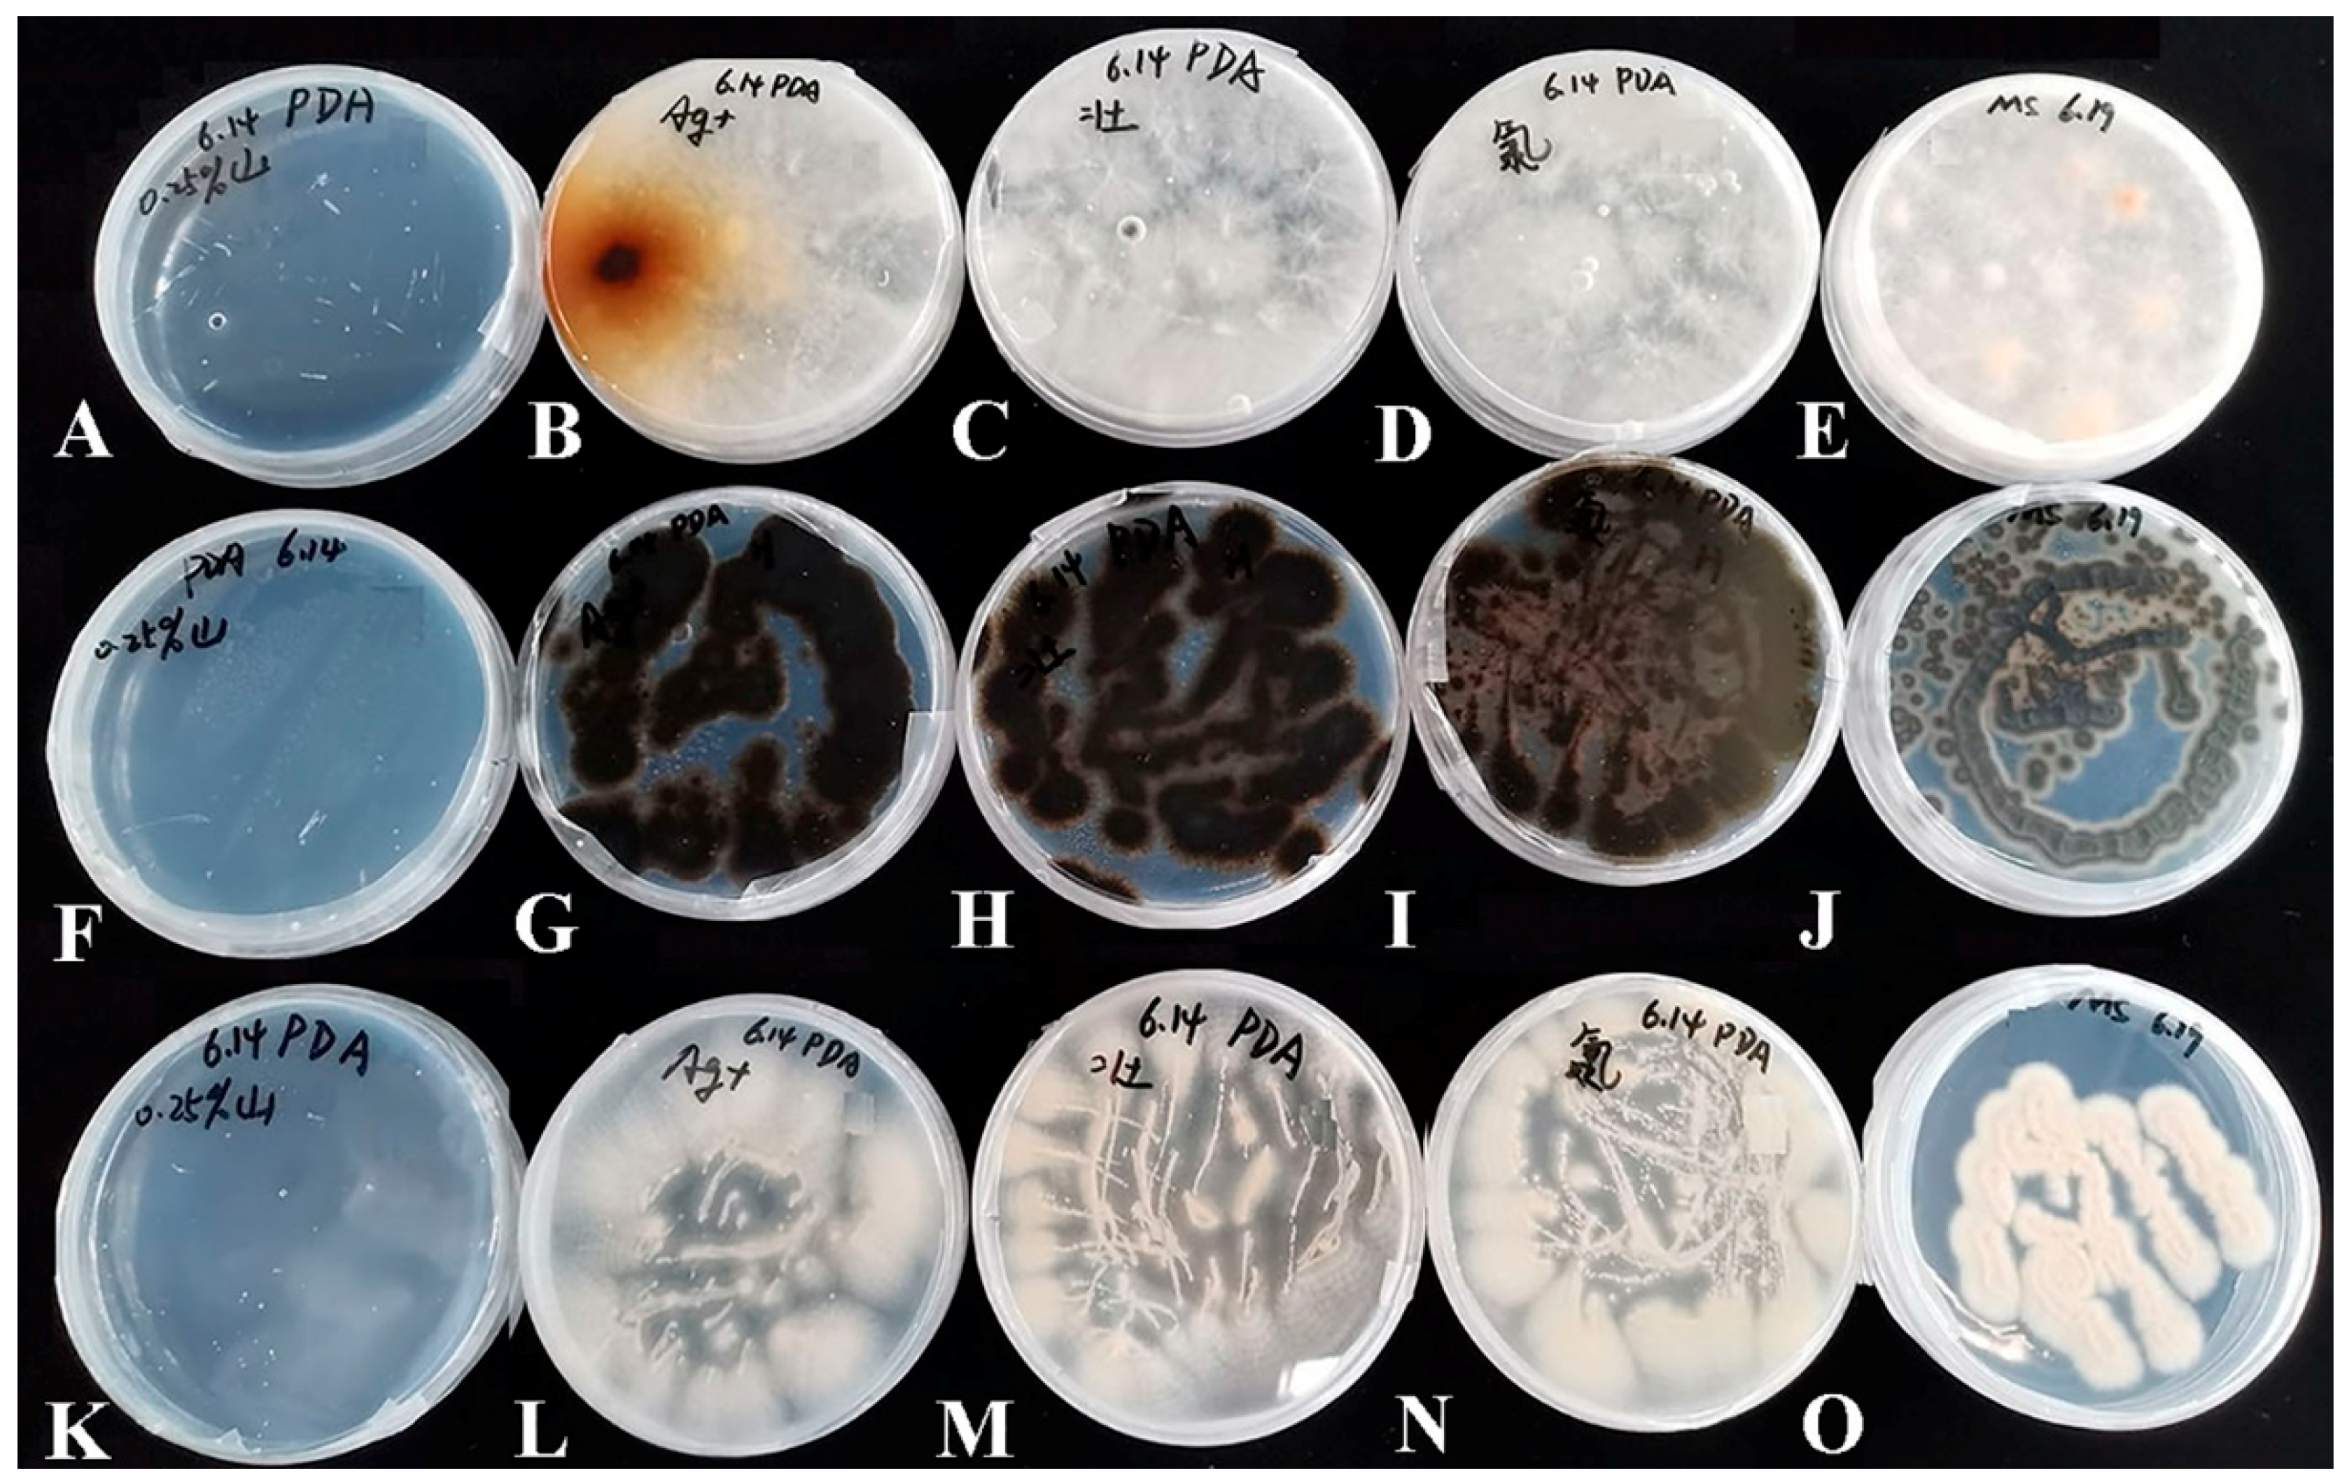
Microorganisms 10 02476 g006 Microorganisms 10 02476 g006

Isolation, Identification and Pollution Prevention of Bacteria and Fungi during the Tissue Culture of Dwarf Hygro (Hygrophila polysperma) Explants
Abstract
1. Introduction
2. Materials and Methods
2.1. Plant Material and Culture Conditions
2.2. Isolation and Identification of Bacteria
2.3. Isolation and Identification of Fungi
2.4. Molecular Analysis of Bacteria and Phylogenetic Tree Construction
2.5. Molecular Analysis of Fungi
2.6. Screening Test for Bacterial Inhibition
2.7. Screening Test for Fungal Inhibition
2.8. The Influences of the Antimicrobial Agents on Explants
3. Results
3.1. Phenotypic Profiles of the Microbial Contaminants
3.2. Isolation and Identification of Bacteria and Fungi
3.3. Molecular Analysis of Bacteria and Fungi
3.4. Drugs Screening from Antimicrobial Susceptibility Results
3.5. The Application of Antimicrobial Agents in Tissue Culture
4. Discussion
Supplementary Materials
Author Contributions
Funding
Institutional Review Board Statement
Informed Consent Statement
Data Availability Statement
Conflicts of Interest
References
- Sulaiman, E.S. Development of Sterilization Procedures and In Vitro Studies of Nymphaea lotus. Master’s Thesis, Universiti Putra Malaysia, Serdang, Malaysia, 2004. [Google Scholar]
- Stanly, C.; Bhatt, A.; Keng, K.L. An efficient in vitro plantlet regeneration of Cryptocoryne wendtii and Cryptocoryne becketti through shoot tip culture. Acta Physiol. Plant 2011, 33, 619–624. [Google Scholar] [CrossRef]
- Karataş, M.; Aasim, M.; Çınar, A.; Dogan, M. Adventitious shoot regeneration from leaf explant of dwarf hygro (Hygrophila polysperma (Roxb.) T. Anderson). Sci. World J. 2013, 2013, 680425. [Google Scholar] [CrossRef] [PubMed]
- Dogan, M. The effectiveness of light emitting diodes on shoot regeneration in vitro from shoot tip tissues of Limnophila aromatica (Lamk.) Merr. and Rotala rotundifolia (Buch-Ham. ex Roxb) Koehne. Biotech. Histochem. 2020, 95, 225–232. [Google Scholar] [CrossRef] [PubMed]
- Kim, D.H.; Gopal, J.; Sivanesan, I. Nanomaterials in plant tissue culture: The disclosed and undisclosed. RSC Adv. 2017, 7, 36492–36505. [Google Scholar] [CrossRef]
- Sivanesan, I.; Muthu, M.; Gopal, J.; Tasneem, S.; Kim, D.H.; Oh, J.W. A fumigation-based surface sterilization approach for plant tissue culture. Int. J. Environ. Res. Public Health 2021, 18, 2282. [Google Scholar] [CrossRef]
- Hardoim, P.R.; van Overbeek, L.S.; Elsas, J.D. Properties of bacterial endophytes and their proposed role in plant growth. Trends Microbiol. 2008, 16, 463–471. [Google Scholar] [CrossRef]
- Thomas, P.; Sekhar, A.C.; Shaik, S.P. High taxonomic diversity of cultivation-recalcitrant endophytic bacteria in grapevine field shoots, their in vitro introduction, and unsuspected persistence. Planta 2017, 246, 879–898. [Google Scholar] [CrossRef]
- Thomas, P.; Franco, C.M.M. Intracellular bacteria in plants: Elucidation of abundant and diverse cytoplasmic bacteria in healthy plant cells using in vitro cell and callus cultures. Microorganisms 2021, 9, 269. [Google Scholar] [CrossRef]
- Rana, K.L.; Kour, D.; Kaur, T.; Devi, R.; Yadav, A.N.; Yadav, N.; Dhaliwal, H.S.; Saxena, A.K. Endophytic microbes: Biodiversity, plant growth-promoting mechanisms and potential applications for agricultural sustainability. Antonie Van Leeuwenhoek 2020, 113, 1075–1107. [Google Scholar] [CrossRef]
- McInroy, J.A.; Kloepper, J.W. Survey of indigenous bacterial endophytes from cotton and sweet corn. Plant Soil 1995, 173, 337–342. [Google Scholar] [CrossRef]
- Sturz, A.V.; Christie, B.R.; Matheson, B.G. Association of bacterial endophyte populations from red clover and potato crops with potential for beneficial allelopathy. Can. J. Microbiol. 1998, 44, 162–167. [Google Scholar] [CrossRef]
- Habiba, U.; Reza, S.; Saha, M.L.; Khan, M.R.; Hadiuzzaman, S. Endogenous bacterial contamination during in vitro culture of banana: Identification and prevention. Plant Tissue Cult. 2002, 12, 117–124. [Google Scholar]
- Compant, S.; Kaplan, H.; Sessitsch, A.; Nowak, J.; Ait Barka, E.; Clément, C. Endophytic colonization of Vitis vinifera L. by Burkholderia phytofirmans strain PsJN: From the rhizosphere to inflorescence tissues. FEMS Microbiol. Ecol. 2008, 63, 84–93. [Google Scholar] [CrossRef] [PubMed]
- Trust, T.J.; Bartlett, K.H. Isolation of Pseudomonas aeruginosa and other bacterial species from ornamental aquarium plants. Appl. Environ. Microbiol. 1976, 31, 992–994. [Google Scholar] [CrossRef] [PubMed]
- Teixeira da Silva, J.A.; Nhut, D.T.; Tanaka, M.; Fukai, S. The effect of antibiotics on the in vitro growth response of chrysanthemum and tobacco stem transverse thin cell layers (tTCLs). Sci. Hortic. 2003, 97, 397–410. [Google Scholar] [CrossRef]
- Mantell, S.H. Microbes intimately associated with tissue and cell cultures of tropical Dioscorea yams. Plant Cell Tissue Org. 1998, 52, 47–52. [Google Scholar] [CrossRef]
- Stout, L.M.; Dodova, E.N.; Tyson, J.F.; Nusslein, K. Phytoprotective influence of bacteria on growth and cadmium accumulation in the aquatic plant Lemna minor. Water Res. 2010, 44, 4970–4979. [Google Scholar] [CrossRef]
- Quambusch, M.; Brümmer, J.; Haller, K.; Winkelmann, T.; Bartsch, M. Dynamics of endophytic bacteria in plant in vitro culture: Quantification of three bacterial strains in Prunus avium in different plant organs and in vitro culture phases. Plant Cell Tissue Organ 2016, 126, 305–317. [Google Scholar] [CrossRef]
- Bolton, J.J. What is aquatic botany and why algae are plants-the importance of non-taxonomic terms for groups of organisms. Aquat. Bot. 2016, 132, 1–4. [Google Scholar] [CrossRef]
- Horppila, J.; Nurminen, L. Effects of submerged macrophytes on sediment resuspension and internal phosphorus lading in Lake Hiidenvesi (southern Finland). Water Res. 2003, 37, 4468–4474. [Google Scholar] [CrossRef]
- Gu, C.G.; Li, F.F.; Xiao, J.B.; Chu, S.Y.; Song, S.; Wong, M.H. A novel submerged Rotala rotundifolia, its growth characteristics and remediation potential for eutrophic waters. Sci. Rep. 2019, 9, 14855. [Google Scholar] [CrossRef] [PubMed]
- Espinoza-Quiñones, F.R.; Zacarkim, C.E.; Palacio, S.M.; Obregόn, C.L.; Zenatti, D.C.; Galante, R.M.; Rossi, N.; Rossi, F.L.; Pereira, I.R.A.; Welter, R.A.; et al. Removal of heavy metal from polluted river water using aquatic macrophytes Salvinia sp. Braz. J. Phys. 2005, 35, 744–746. [Google Scholar] [CrossRef]
- Zhang, Y.; Wang, Y.; Yang, B.; Chen, S. In vitro regeneration and propagation of Pistia stratiotes: An ideal aquatic plant for biomanufacturing and bioremediation. Chin. J. Appl. Environ. Biol. 2008, 4, 445–449. [Google Scholar]
- Carlos, A.; Harguinteguy, M.; Pignata, L.; Fernández-Cirelli, A. Nickel, lead and zinc accumulation and performance in relation to their use in phytoremediation of macrophytes Myriophyllum aquaticum and Egeria densa. Ecol. Eng. 2015, 82, 512–516. [Google Scholar] [CrossRef]
- Hanks, N.A.; Caruso, J.A.; Zhang, P. Assessing Pistia stratiotes for phytoremediation of silver nanoparticles and Ag(I) contaminated waters. J. Environ. Manag. 2015, 164, 41–45. [Google Scholar] [CrossRef]
- Ebrahimbabaie, P.; Meeinkuirt, W.; Pichtel, J. Phytoremediation of engineered nanoparticles using aquatic plants: Mechanisms and practical feasibility. J. Environ. Sci. 2020, 93, 151–163. [Google Scholar] [CrossRef]
- Antunes, C.; Correia, O.; Silva, J.M.; Cruces, A.; Freitas, M.C.; Branquinho, C. Factors involved in spatiotemporal dynamics of submerged macrophytes in a portuguese coastal lagoon under mediterranean climate. Estuar. Coast. Shelf Sci. 2012, 110, 93–100. [Google Scholar] [CrossRef]
- Arefin, M.A.; Rashid, F.; Islam. A review of biofuel production from floating aquatic plants: An emerging source of bio-renewable energy. Biofuels Bioprod. Biorefining 2021, 15, 574–591. [Google Scholar] [CrossRef]
- Tan, Q.G.; Cai, X.H.; Feng, T.; Luo, X.D. Megastigmane-type compounds from Rotala rotundifolia. Chin. J. Nat. Med. 2009, 7, 187–189. [Google Scholar] [CrossRef]
- Kshirsagar, A.; Ingale, K.; Vyawahare, N.; Thorve, V. Hygrophila spinosa: A comprehensive review. Pharmacogn. Rev. 2010, 4, 167–171. [Google Scholar] [CrossRef]
- Swapna, M.M.; Prakashkumar, R.; Anoop, K.P.; Manju, C.N.; Rajith, N.P. A review on the medicinal and edible aspects of aquatic and wetland plants of India. J. Med. Plants Res. 2011, 5, 7163–7176. [Google Scholar] [CrossRef]
- Zhang, L.J.; Yeh, S.F.; Yu, Y.T.; Kuo, L.-M.Y.; Kuo, Y.H. Antioxidative flavonol glucuronides and anti-HBsAg flavonol from Rotala rotundifolia. J. Tradit. Complement Med. 2011, 1, 57–63. [Google Scholar] [CrossRef] [PubMed]
- Rosen, D.J. Cryptocoryne beckettii (Araceae), a new aquatic plant in Texas. Sidahora 2000, 19, 399–401. [Google Scholar]
- Maki, K.; Galatowitsch, S. Movement of invasive aquatic plants into Minnesota (USA) through horticultural trade. Biol. Conserv. 2004, 118, 389–396. [Google Scholar] [CrossRef]
- Murashige, T.; Skoog, F. A revised medium for rapid growth and bioassays with tobacco tissue cultures. Physiol. Plant. 1962, 15, 473–497. [Google Scholar] [CrossRef]
- Weisburg, W.G.; Barns, S.M.; Pelletier, D.A.; Lane, D.J. 16S ribosomal DNA amplification for phylogenetic study. J. Bacteriol. 1991, 173, 697–703. [Google Scholar] [CrossRef]
- Saitou, N.; Nei, M. The neighbor-joining method: A new method for reconstructing phylogenetic trees. Mol. Biol. Evol. 1987, 4, 406–425. [Google Scholar] [CrossRef]
- Kimura, M. A simple method for estimating evolutionary rate of base substitutions through comparative studies of nucleotide sequences. J. Mol. Evol. 1980, 16, 111–120. [Google Scholar] [CrossRef]
- Wu, S.M.; Liu, G.; Jin, W.H.; Xiu, P.Y.; Sun, C.M. Antibiofilm and anti-Infection of a marine bacterial exopolysaccharide against Pseudomonas aeruginosa. Front. Microbiol. 2016, 7, 102. [Google Scholar] [CrossRef]
- Lewis, M.; Thursby, G. Aquatic plants: Test species sensitivity and minimum data requirement evaluations for chemical risk assessments and aquatic life criteria development for the USA. Environ. Pollut. 2018, 238, 270–280. [Google Scholar] [CrossRef]
- Jenks, M.A.; Kane, M.E.; McConnell, D.B. Shoot organogenesis from petiole explants in the aquatic plant Nymphoides indica. Plant Cell Tissue Organ Cult. 2000, 63, 1–8. [Google Scholar] [CrossRef]
- Huang, L.; Chang, Y.; Chang, Y. Rapid in vitro multiplication of the aquatic angiosperm, Anubias barteri var undulata. Aquat. Bot. 1994, 47, 77–83. [Google Scholar] [CrossRef]
- Ozturk, M.; Khawar, K.M.; Atar, H.H.; Sancak, C.; Ozcan, S. In vitro micropropagation of aquarium plant Ludwigia repens. Asia Pac. J. Mol. Biol. Biotechnol. 2004, 12, 21–25. [Google Scholar]
- Kane, M.E.; Davis, G.L.; McConnell, D.B.; Gargiulo, J.A. In vitro propagation of Cryptocoryne wendtii. Aquat. Bot. 1999, 63, 197–202. [Google Scholar] [CrossRef]
- Kane, M.E.; Gilman, E.F.; Jenks, M.A.; Sheehan, T.J. Micropropagation of the aquatic plant Cryptocoryne lucens. Hort. Sci. 1990, 25, 687–689. [Google Scholar] [CrossRef]
- Mo, X.; Jiang, Q. Study on rapid proliferation and color appearing of tropical aquatic grass Cryptocoryne wendtii tropica. Acta Agric. Zhejiangensis 2003, 15, 91–94. [Google Scholar]
- Volk, G.M.; Bonnart, R.; de Oliveira, A.C.A.; Henk, A.D. Minimizing the deleterious effects of endophytes in plant shoot tip cryopreservation. Appl. Plant Sci. 2022, 10, e11489. [Google Scholar] [CrossRef]
- Rosenblueth, M.; Martinez-Romero, E. Bacterial endophytes and their interactions with hosts. Mol. Plant Microbe Interact. 2006, 19, 827–837. [Google Scholar] [CrossRef]
- Pirttilä, A.M.; Laukkanen, H.; Pospiech, H.; Myllylä, R.; Hohtola, A. Detection of intracellular bacteria in the buds of Scotch pine (Pinus sylvestris L.) by in situ hybridization. Appl. Environ. Microbiol. 2000, 66, 3073–3077. [Google Scholar] [CrossRef]
- Compant, S.; Clement, C.; Sessitsch, A. Plant growth-promoting bacteria in the rhizo- and endosphere of plants: Their role, colonization, mechanisms involved and prospects for utilization. Soil Biol. Biochem. 2010, 42, 669–678. [Google Scholar] [CrossRef]
- Bragina, A.; Berg, C.; Cardinale, M.; Shcherbakov, A.; Chebotar, V.; Berg, G. Sphagnum mosses harbour highly specific bacterial diversity during their whole lifecycle. ISME J. 2012, 6, 802–813. [Google Scholar] [CrossRef] [PubMed]
- Hardoim, P.R.; van Overbeek, L.S.; Berg, G.; Pirttilä, A.M.; Compant, S.; Campisano, A.; Döring, M.; Sessitsch, A. The hidden world within plants: Ecological and evolutionary considerations for defining functioning of microbial endophytes. Microbiol. Mol. Biol. Rev. 2015, 79, 293–320. [Google Scholar] [CrossRef] [PubMed]
- Tsoktouridis, G.; Tsiamis, G.; Koutinas, N.; Mantell, S. Molecular detection of bacteria in plant tissues, using universal 16S ribosomal DNA degenerated primers. Biotechnol. Biotechnol. Equip. 2014, 28, 583–591. [Google Scholar] [CrossRef] [PubMed]
- Edgar, R.C. Updating the 97% identity threshold for 16S ribosomal RNA OTUs. Bioinformatics 2018, 34, 2371–2375. [Google Scholar] [CrossRef] [PubMed]
- Berg, G.; Rybakova, D.; Grube, M.; KÖberl, M. The plant microbiome explored: Implications for experimental botany. J. Exp. Bot. 2016, 77, 995–1002. [Google Scholar] [CrossRef]
- Sturz, A.V.; Nowak, J. Endophytic communities of rhizobacteria and the strategies required to create yield enhancing associations with crops. Appl. Soil Ecol. 2000, 15, 183–190. [Google Scholar] [CrossRef]
- Leifert, C.; Cassells, A. Microbial hazards in plant tissue and cell cultures. In Vitro Cell Dev. Biol. Plant 2001, 37, 133–138. [Google Scholar] [CrossRef]
- Tsavkelova, E.A.; Cherdyntseva, T.A.; Netrusov, A.I. Auxin production by bacteria associated with orchid roots. Microbiology 2005, 74, 46–53. [Google Scholar] [CrossRef]
- Ali, B.; Sabri, A.N.; Ljung, K.; Hasnain, S. Auxin production by plant associated bacteria: Impact on endogenous IAA content and growth of Triticum aestivum L. Lett. Appl. Microbiol. 2009, 48, 542–547. [Google Scholar] [CrossRef]

| Bacterial Names | Abbreviations | Characteristics |
|---|---|---|
| Kosakonia oryzendophytica strain | Ko | white |
| Pantoea sp. strain BHUJPCS-26 | BH | white |
| Bacillus amyloliquefaciens strain BV2007 | BV | wrinkled |
| Bacillus siamensis strain | Bsi | wrinkled |
| Bacillus subtilis strain | Bsu | Mucus |
| Bacillus amyloliquefaciens strain Y5 | Y5 | Mucus |
| Bacillus koreensis strain | Bk | Mucus |
| Bacillus aryabhattai strain B8W22T.35 | B8 | Mucus |
| Ensifer sp. strain BO-30 | BO | droplet |
| Bacillus zanthoxyli strain | Bz | Dry white sediment |
| Bacillus aryabhattai strain WH6 | Ba | Dry white sediment |
| Enterobactercloacae strain PR3 | Ec | Light yellow |
| Klebsiella michiganensis strain | Km | Yellow |
| Enterobacter sp. strain Glu2 | Glu2 | Yellow |
| Enterobacter sp. strain E24 | E24 | Yellow |
| Fungal Names | Abbreviations | Characteristics |
|---|---|---|
| Peniophora sp. strain | Pe | White villus |
| Plectosphaerella oligotrophica strain | Po | Tasteless white villus |
| Cladosporium crousii strain | Cc | Tasteless green villus |
| Bacterial Name | Kan | Amp | Ery | Spc | Chl | PS |
|---|---|---|---|---|---|---|
| K. oryzendophytica | − | + | + | + | + | + |
| Pantoea BH | − | + | + | + | + | + |
| B. amyloliquefaciens BV | − | + | − | + | + | + |
| B. siamensis | − | + | − | + | − | + |
| B. subtilis | − | + | − | + | − | + |
| B. amyloliquefaciens Y5 | − | + | − | − | − | + |
| B. koreensis | − | + | − | + | − | + |
| B. aryabhattai B8 | − | + | − | − | − | + |
| Ensifer BO | − | + | + | + | − | + |
| B. zanthoxyli | − | − | − | − | − | + |
| B. aryabhattai WH6 | − | + | − | + | − | + |
| E. cloacae | − | + | − | + | − | + |
| K. michiganensis | − | + | + | + | + | + |
| Enterobacter Glu2 | + | + | + | + | − | + |
| Enterobacter E24 | + | + | + | + | − | + |
Publisher’s Note: MDPI stays neutral with regard to jurisdictional claims in published maps and institutional affiliations. |
© 2022 by the authors. Licensee MDPI, Basel, Switzerland. This article is an open access article distributed under the terms and conditions of the Creative Commons Attribution (CC BY) license (https://creativecommons.org/licenses/by/4.0/).
Share and Cite
Li, W.; Cao, G.; Zhu, M.; Zhang, Y.; Zhou, R.; Zhao, Z.; Guo, Y.; Yang, W.; Zheng, B.; Tan, J.; et al. Isolation, Identification and Pollution Prevention of Bacteria and Fungi during the Tissue Culture of Dwarf Hygro (Hygrophila polysperma) Explants. Microorganisms 2022, 10, 2476. https://doi.org/10.3390/microorganisms10122476
Li W, Cao G, Zhu M, Zhang Y, Zhou R, Zhao Z, Guo Y, Yang W, Zheng B, Tan J, et al. Isolation, Identification and Pollution Prevention of Bacteria and Fungi during the Tissue Culture of Dwarf Hygro (Hygrophila polysperma) Explants. Microorganisms. 2022; 10(12):2476. https://doi.org/10.3390/microorganisms10122476
Chicago/Turabian StyleLi, Weijie, Guanglong Cao, Mengqian Zhu, Yilin Zhang, Rong Zhou, Zhenyang Zhao, Yaning Guo, Wanli Yang, Bo Zheng, Jiabo Tan, and et al. 2022. "Isolation, Identification and Pollution Prevention of Bacteria and Fungi during the Tissue Culture of Dwarf Hygro (Hygrophila polysperma) Explants" Microorganisms 10, no. 12: 2476. https://doi.org/10.3390/microorganisms10122476
APA StyleLi, W., Cao, G., Zhu, M., Zhang, Y., Zhou, R., Zhao, Z., Guo, Y., Yang, W., Zheng, B., Tan, J., & Sun, Y. (2022). Isolation, Identification and Pollution Prevention of Bacteria and Fungi during the Tissue Culture of Dwarf Hygro (Hygrophila polysperma) Explants. Microorganisms, 10(12), 2476. https://doi.org/10.3390/microorganisms10122476

